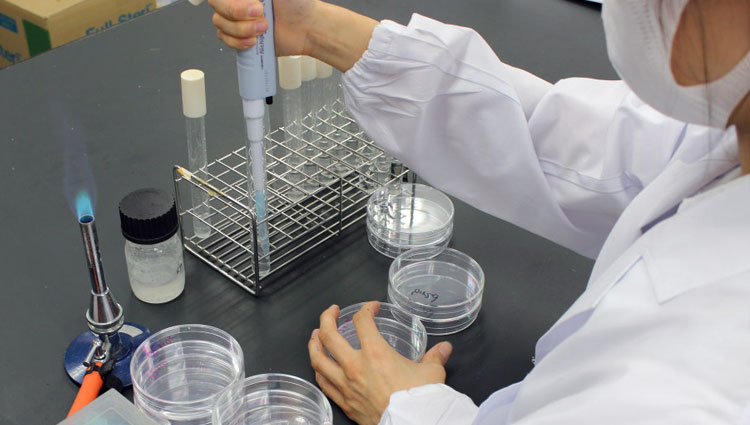

水質検査
- M-LEMトップ
- 公衆浴場法に基づく検査
- 水質検査
水質検査について
検査方法
マルマでは、「公衆浴場における衛生等管理要領等」に基づいた検査方法を行っています。
レジオネラ属菌の検査は遺伝子検査法も取り入れております。
レジオネラ属菌の検査は遺伝子検査法も取り入れております。
項目 | 基準値 |
---|---|
色度 | 比色法または透過光測定法 |
濁度 | 比濁法または積分球式光電光度法 |
pH値 | ガラス電極法 |
有機物等(全有機炭素(TOC)の量または過マンガン酸ナトリウム消費量) | 全有機炭素(TOC)の量:全有機炭素計測定法 過マンガン酸ナトリウム消費量:滴定法 |
大腸菌 | 特定酵素基質培地法 |
レジオネラ属菌 | 冷却遠心濃縮法、ろ過濃縮法またはLC EMA-qPCR法 |

検査の流れ
ご依頼
打合せ(検査項目および検体数の聞き取り、お見積書の提出)検査
弊社スタッフによるサンプリング、お客様によるサンプリング後の郵送または持込み検査(公定法に基づいた検査)
報告
弊社様式成績書による結果報告